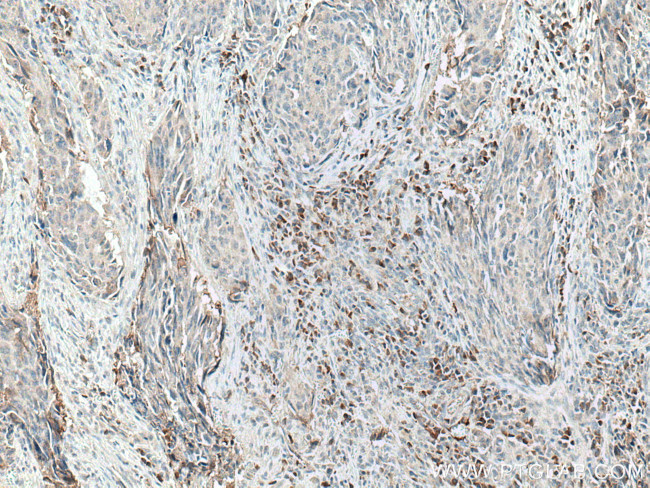
CXCL11 Antibody in Immunohistochemistry (Paraffin) (IHC (P))

Search
Proteintech
CXCL11 Polyclonal Antibody
{{$productOrderCtrl.translations['antibody.pdp.commerceCard.promotion.promotions']}}
{{$productOrderCtrl.translations['antibody.pdp.commerceCard.promotion.viewpromo']}}
{{$productOrderCtrl.translations['antibody.pdp.commerceCard.promotion.promocode']}}: {{promo.promoCode}} {{promo.promoTitle}} {{promo.promoDescription}}. {{$productOrderCtrl.translations['antibody.pdp.commerceCard.promotion.learnmore']}}
产品信息
10707-1-AP
种属反应
宿主/亚型
分类
类型
抗原
偶联物
形式
浓度
规格
纯化类型
保存液
内含物
保存条件
运输条件
产品详细信息
Aliquoting is unnecessary for -20°C storage.
靶标信息
Interferon-inducible T-cell alpha chemoattractant ( I-TAC), belonging to the CXC chemokine family, is expressed in peripheral blood leukocytes, pancreas and liver, thymus, spleen, lung, small intestine, placenta and prostate. Its molecular weight is 8-11 kD. I-TAC is also known as CXCL-11 and IP-9. The cytokine is involved in regulating calcium release and inducing a chemotactic response in activated T-cells and is the dominant ligand for CXC receptor-3. The gene encoding this protein contains 4 exons and at least three polyadenylation signals which might reflect cell-specific regulation of expression. IFN-gamma is a potent inducer of transcription of this gene. It is upregulated in patients with AIDS, dementia and in patients with multiple sclerosis.
仅用于科研。不用于诊断过程。未经明确授权不得转售。
篇参考文献 (0)
生物信息学
蛋白别名: Beta-R1; C Cmotif chemokine; C X C motif chemokine; C-X-C motif chemokine 11; CC motif chemokine; CCmotif chemokine; chemokine; chemokine (C-X-C motif) ligand 11; CXC; CXC motif chemokine; CXCL; H174; I-TAC; Interferon gamma-inducible protein 9; Interferon-inducible T-cell alpha chemoattractant; IP-9; MGC102770; small inducible cytokine B11; small inducible cytokine subfamily B (Cys-X-Cys), member 11; small inducible cytokine subfamily B (Cys-X-Cys), member 9B; Small-inducible cytokine B11
基因别名: b-R1; CXCL11; H174; I-TAC; IP-9; IP9; ITAC; SCYB11; SCYB9B
UniProt ID: (Human) O14625
Entrez Gene ID: (Human) 6373